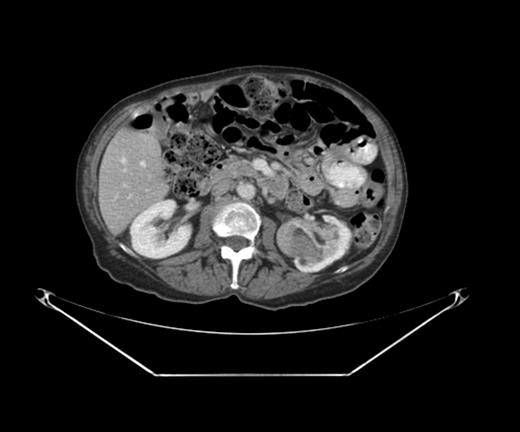
CT scan with the left renal mass.

-
PDF
- Split View
-
Views
-
Cite
Cite
Emilia Diego, Kandace P McGuire, A rare case of tumor-to-tumor metastasis: breast cancer metastatic to a benign renal mass, Journal of Surgical Case Reports, Volume 2013, Issue 2, February 2013, rjt006, https://doi.org/10.1093/jscr/rjt006
Close - Share Icon Share
Abstract
Tumor-to-tumor metastasis is a clinical entity that has been documented in medical literature as early as the 1900s. It is rare and published primarily as case reports, although its incidence seems to be on the rise as a result of improving medical care in developed countries. We report an unusual case of metatstatic breast tumor to a benign renal tumor, in a patient with a remote history of breast cancer. This case reinforces in our minds the enigmatic nature of breast cancer and its wide spectrum of clinical behavior.
INTRODUCTION
Tumor-to-tumor metastasis, although uncommon, is not as rare as once thought. Since Berent's first documentation of a case in 1902 [1], over 150 cases have been reported in literature [2].
The most commonly reported recipient tumor is a renal cell carcinoma [3] and there are several theories to support this phenomenon. Pulmonary carcinoma is noted to be the most frequent donor tumor [4] but other tumors are also known to metastasize, including breast, gastrointestinal, prostate and thyroid cancers [1].
We report an unusual case of tumor-to-tumor metastasis that involves a benign recipient tumor.
CASE REPORT
A 67-year-old Caucasian female presented for evaluation of a right chest wall mass 19 years after a modified radical mastectomy for a Stage IIB hormone-receptor positive invasive ductal carcinoma. She received adjuvant chemotherapy and endocrine therapy and had been symptom free until presentation.
A PET-CT was performed, which demonstrated a round enhancing 1.8 × 1.5 cm right subpectoral lymph node with FDG uptake and a maximum SUV of 4.0 suspicious for metastatic disease (Figs 1 and 2). Additionally, an incidental 4.1 × 3.4 cm mass within the midpole of the left kidney was heterogeneously enhancing with increased FDG uptake and a maximum SUV of 8.6 suspicious for a renal cell carcinoma or less likely a transitional cell carcinoma (Figs 3 and 4).

An ultrasound guided core biopsy of the subpectoral lymph node verified metastatic carcinoma of breast origin, confirmed by positive immunostaining for mammaglobulin, e-cadherin and estrogen receptors (Fig. 5).

Microscopic findings of the subpectoral lymph node: H&E stain (A, B); E-cadherin and p120 dural stain to confirm the ductal nature of the cancer (C); ER staining (D).
With the relatively small burden of metastatic breast disease, surgical management for the renal mass was deemed appropriate and she underwent a left total nephrectomy without complications.
The kidney measured 10.5 × 7.5 × 5.5 cm and was distorted by a 6.0 × 5.5 × 4.0 cm tan-brown mass with a pseudocapsule at the inferior pole (Fig. 6). Within the tan-brown mass was a centrally located 2.0 × 1.5 cm white mass (Fig. 7).


Photograph of the gross specimen, left kidney focusing on tumor.
The final pathology demonstrated a 2 cm metastatic mammary carcinoma within a 6 cm angiomyolipoma, confirmed by staining with melan A. All the margins were clear and the renal parenchyma was uninvolved. The metastatic focus was composed of cytologically atypical glands with intraluminal blue mucin, morphologically similar to the subpectoral lymph node biopsy. The metastatic cells also stained positive for the estrogen receptor, mammaglobulin and GCDFP-15, confirming the tumor to be of breast origin (Fig. 8).

Microscopic findings of left nephrectomy: H&E stain (A, B), with insert in B demonstrating melan A stain to confirm the AML; mammaglobin stain (C); Estrogen receptor stain (D), with insert demonstrating GCDFP15 stain.
The patient did well post-operatively and was discharged home in a timely fashion after her nephrectomy. At her 7 month follow-up, she continues to take anti-estrogen hormonal therapy and has no demonstrable progression of disease. She has been offered surgical excision of the subpectoral lymph node, but declines at this time.
DISCUSSION
With the improvement in cancer care and increased life expectancy in the US, tumor-to-tumor metastasis may become a more frequently encountered clinical scenario.
Campbell et al. [5] first defined tumor-to-tumor mestastasis in 1968 with the following criteria: (i) documentation of more than one primary tumor; (ii) the recipient tumor is a true neoplasm; (iii) the second neoplasm is a true metastasis with established growth or invasion in the host and not a result of contiguous growth or embolization of tumor cells; and (iv) tumors that have metastasized to the lymphatic system, where lymphoreticular malignant disease already exists, are excluded.
Renal cell carcinomas are overwhelmingly the most common recipient tumor involved in tumor-to-tumor metastasis. Two theories supporting this phenomenon include: (i) the rich vascularity of the kidney and renal cell carcinomas and (ii) the high lipid and glycogen content of renal cell carcinomas, which make them a favorable, nutrient-rich environment for metastasis [6].
Although tumor-to-tumor metastasis has been reported with benign recipient tumors, the occurrence is less common. Recipient tumors that have been reported include endocrine adenomas, angiomyolipomas [7], meningiomas [8, 9] and uterine leiomyomas [10]. In such cases, lung and breast cancers proved to be the most common donor tumor [9].
Our current case, however, involves metastasis of a breast carcinoma to a benign renal angiomyolipoma, a scenario that was not diagnosed or expected pre-operatively, but one that significantly affects her prognosis. Only one other such case has been reported in a patient with tuberous sclerosis complex and multiple renal angiomyolipomas with a distant history of breast cancer [7].
The occurrence of tumor-to-tumor metastasis remains a rare phenomenon that may become a more common clinical entity with improvements in health care in developed countries and the increasing life expectancy, proving the point that a distant history of cancer should always raise suspicion of a recurrence. This case also reminds us of the enigmatic nature of breast cancer and its behavior: although metastatic, it can be indolent and slow-growing to allow detection before local symptoms arise.
Acknowledgements
The authors thank Xin Li and Michael Mishra of the University of Pittsburgh Medical Center for supplying images from pathology and radiology.